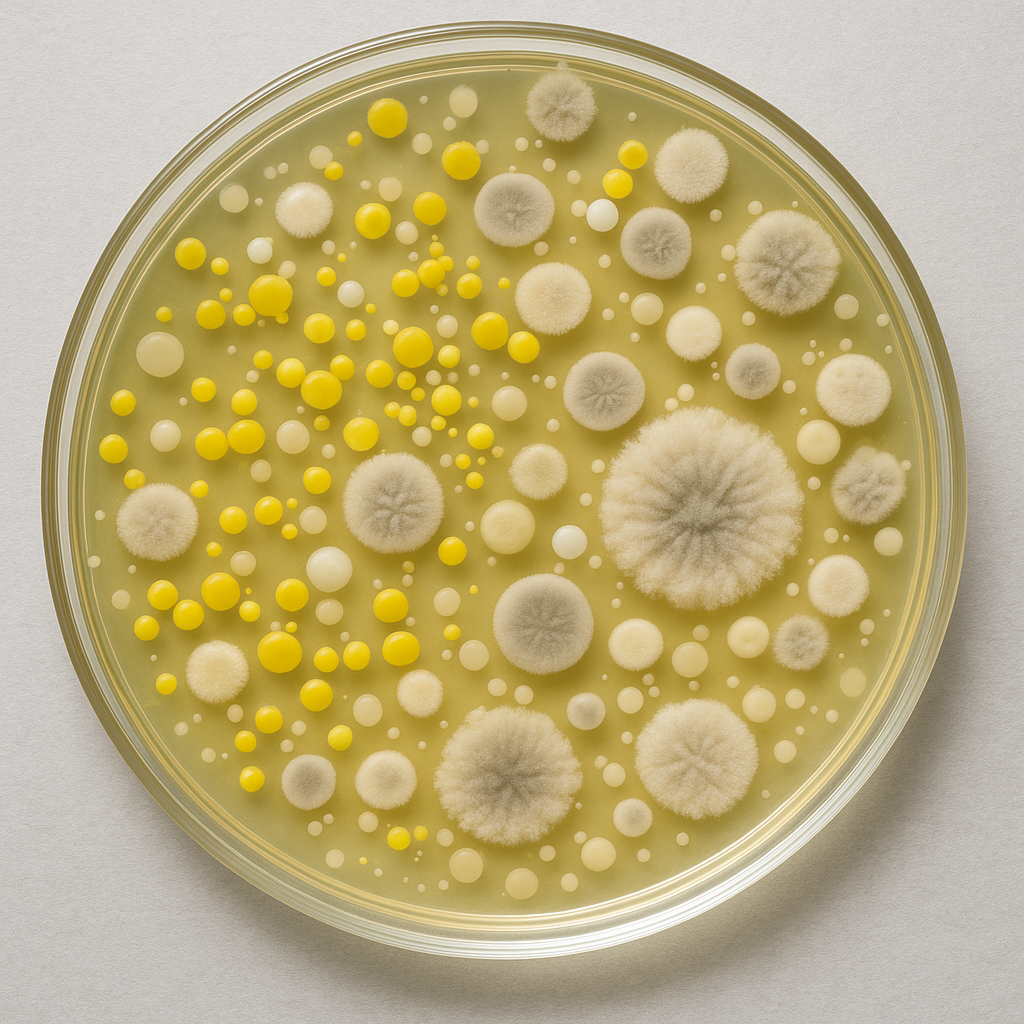

Air Clearance Testing
Air Clearance Testing ensures that your space is safe to reoccupy after asbestos, mold, or other hazardous material remediation. Using precise air sampling equipment, we test for airborne contaminants to confirm that cleanup efforts meet health and safety standards. It’s the final step in making sure your environment is clean, clear, and compliant.